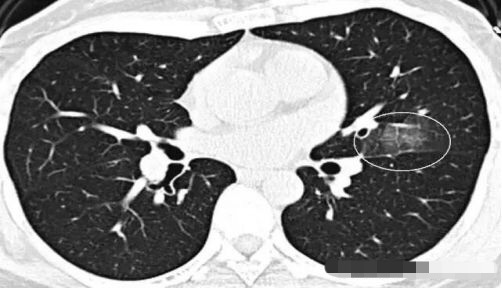
8069275_9.jpeg

一、肺磨玻璃结节是神马东东?
肺磨玻璃结节英文叫GGO(GGN),指在胸部CT检查时发现,表现为密度轻度增高的云雾状淡薄影/圆形结节,样子像磨砂玻璃一样,所以叫磨玻璃影。可以是弥漫性散在生长,也可以仅聚集在局部,看起来像一个小磨玻璃结节。一般而言,弥漫性生长的多数是良性病变,局灶性生长的容易是不好的东东。

二、这些磨玻璃影是肺癌吗?
大家不要谈到肺磨玻璃影就色变,不一定是癌。有时候,肺部炎症、 出血、 纤维化(炎症后遗留的瘢痕)都可以造成此变化,然而,在更多的时候还是恶性的。
请问王大夫,这个那么像磨砂玻璃,这种是肺癌吗?

不是的,这个是肺泡蛋白沉积症,患者的肺像铺路石一样。
2. 那么,王大夫,这个磨玻璃影那么多,是不是也是肺癌呢?

一、肺磨玻璃结节是神马东东?
肺磨玻璃结节英文叫GGO(GGN),指在胸部CT检查时发现,表现为密度轻度增高的云雾状淡薄影/圆形结节,样子像磨砂玻璃一样,所以叫磨玻璃影。可以是弥漫性散在生长,也可以仅聚集在局部,看起来像一个小磨玻璃结节。一般而言,弥漫性生长的多数是良性病变,局灶性生长的容易是不好的东东。

二、这些磨玻璃影是肺癌吗?
大家不要谈到肺磨玻璃影就色变,不一定是癌。有时候,肺部炎症、 出血、 纤维化(炎症后遗留的瘢痕)都可以造成此变化,然而,在更多的时候还是恶性的。
请问王大夫,这个那么像磨砂玻璃,这种是肺癌吗?
不是的,这个是肺泡蛋白沉积症,患者的肺像铺路石一样。
2. 那么,王大夫,这个磨玻璃影那么多,是不是也是肺癌呢?
呵呵,这个也不是啦,这个叫马赛克灌注,是肺内通气灌注不一致的表现,主要是小支气管炎症,导致肺内局部积气,像马赛克拼图一样。不是肺癌,当然不用担心啦。
3.元芳,你看,这个也像GGO,还有一个小空洞,但它是一个隐球菌感染(肺里面长蘑菇了),不是肺癌,不用担心。

4. 王医生,你看,这个人到处都是GGO,怎么办?
元芳,你仔细看,它是弥漫性的磨玻璃影,这是肺淋巴管平滑肌肌瘤病,不是肺癌,不用担心。

5. 元芳,你看下图是个肺外伤后的表现,也是弥漫性的GGO

6. 元芳,还有些病人,发现肺部磨玻璃结节前期有大量咯血症状,肺内有磨玻璃结节。这种病人,实际上是肺泡内的积血,这些血没有在咯血的时候排出肺部,积在患者肺内,形成磨玻璃结节。这种磨玻璃结节的特点是周边边缘不清晰,随着时间变化,会逐步缩小或吸收。

7. 元芳,你看,这个磨玻璃影是肺内差异性灌注,主要是肺内不同区域肺通气不同而造成的。

8.元芳,这是肺内炎症后改变 可以看得出明显的肺泡样结构。这种都是良性表现,依靠医生的火眼金睛才能分辨。
9.元芳,这个是肺内炎症后吸收改变,逐步缩小的病史证实其为良性病变


